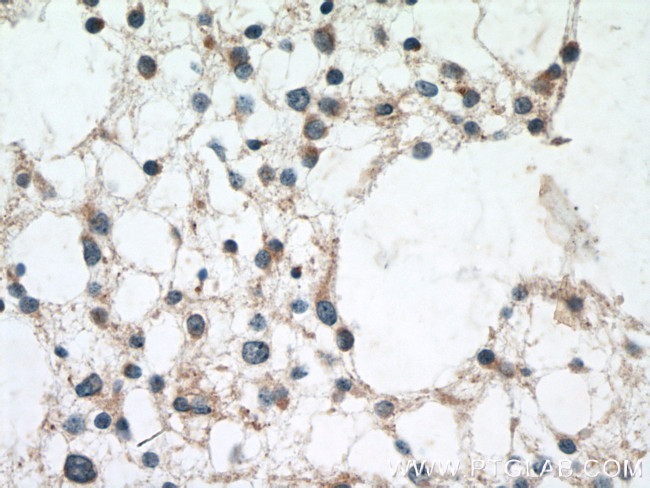
BRE Antibody in Immunohistochemistry (Paraffin) (IHC (P))

Search
Proteintech
BRE Polyclonal Antibody
{{$productOrderCtrl.translations['antibody.pdp.commerceCard.promotion.promotions']}}
{{$productOrderCtrl.translations['antibody.pdp.commerceCard.promotion.viewpromo']}}
{{$productOrderCtrl.translations['antibody.pdp.commerceCard.promotion.promocode']}}: {{promo.promoCode}} {{promo.promoTitle}} {{promo.promoDescription}}. {{$productOrderCtrl.translations['antibody.pdp.commerceCard.promotion.learnmore']}}
产品信息
11702-1-AP
种属反应
已发表种属
宿主/亚型
分类
类型
抗原
偶联物
形式
浓度
规格
纯化类型
保存液
内含物
保存条件
运输条件
产品详细信息
Immunogen sequence: PDPSALQNL ASWNPSNPEC LLLVVKELVQ QYHQFQCSRL RESSRLMFEY QTLLEEPQYG ENMEIYAGKK NNWTGEFSAR FLLKLPVDFS NIPTYLLKDV NEDPGEDVAL LSVSFEDTEA TQVYPKLYLS PRIEHALGGS SALHIPAFPG GGCLIDYVPQ VCHLLTNKVQ YVIQGYHKRR EYIAAFLSHF GTGVVEYDAE GFTKLTLLLM WKDFCFLVHI DLPLFFPRDQ PTLTFQSVYH FTNSGQLYSQ AQKNYPYSPR WDGNEMAKRA KAYFKTFVPQ FQEAAFANGK L (94-383 aa encoded by BC001251)
靶标信息
BRCC45 was initially suggested to be a housekeeping protein that is highly expressed in brain and reproductive organs. Later experiments indicated BRCC45 forms a complex with the breast and ovarian predisposition proteins BRCA1 and BRCA2 as well as RAD51 and BRCC36. This complex has a ubiquitin E3 ligase activity and is thought to enhance cellular survival following DNA damage. BRCC45 has also been suggested to function as a death receptor-associated anti-apoptotic protein by inhibiting the BID-induced activation of the mitochondrial apoptotic pathway. Higher levels of BRCC45 were detected in the majority of hepatocellular carcinomas, suggesting that BRCC45 may promote tumorigenesis when overexpressed. At least three isoforms of BRCC45 are known to exist.
仅用于科研。不用于诊断过程。未经明确授权不得转售。
生物信息学
蛋白别名: brain and reproductive organ-expressed (TNFRSF1A modulator); Brain and reproductive organ-expressed protein; BRCA1-A complex subunit BRE; BRCA1/BRCA2-containing complex subunit 45; BRCA1/BRCA2-containing complex, subunit 4; BRISC and BRCA1-A complex member 2; putative redox regulating protein; unnamed protein product
基因别名: BABAM2; BRCC4; BRCC45; BRE
UniProt ID: (Human) Q9NXR7
Entrez Gene ID: (Human) 9577